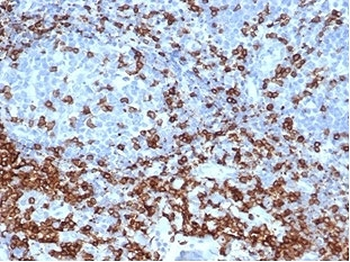
Recombinant CD3e Antibody / CD3 epsilon

You have no items in your shopping cart.
- HLA-DRB1 Antibody (MHC II) [orb749567]
FACS, IF, IHC-P, WB
Human
Mouse
Monoclonal
Unconjugated
100 μg, 20 μg - HLA-DRB1 Antibody (MHC II) [orb749568]
FACS, IF, IHC-P, WB
Human
Mouse
Monoclonal
Unconjugated
100 μg, 20 μg - HLA-DRB1 Antibody (MHC II) [orb749569]
FACS, IF, IHC-P, WB
Human
Mouse
Monoclonal
Unconjugated
100 μg, 20 μg - CD3e Antibody / Cytoplasmic domain [orb750081]
FACS, IF, WB
Human, Mouse, Rat
Mouse
Monoclonal
Unconjugated
100 μg, 20 μg - Recombinant CD3e Antibody / CD3 epsilon [orb2635618]
ELISA, IHC-P, WB
Human
Rabbit
Recombinant
Unconjugated
100 μg